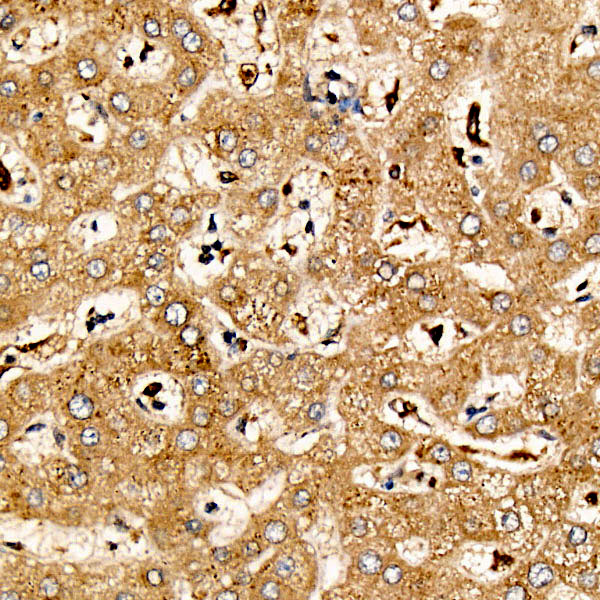

The protein encoded by this gene is a pleiotropic cytokine with roles in several different systems. It is involved in the induction of hematopoietic differentiation in normal and myeloid leukemia cells, induction of neuronal cell differentiation, regulator of mesenchymal to epithelial conversion during kidney development, and may also have a role in immune tolerance at the maternal-fetal interface. Alternatively spliced transcript variants encoding multiple isoforms have been observed for this gene.
| Pack Size | 100ul, 1ml, 20ul |
|---|---|
| Applications | ELISA, IHC-P, WB |
| Host Species | Rabbit |
| Ig Isotype | IgG |
| Antibody Type | Polyclonal Antibody |
| Organism Species | Human |
| Concentration | – |
| Product Synonyms | Lif |
| Observed Mol Wt | 22kDa |
| Alternative Names | CDF; DIA; HILDA; MLPLI; LIF |
| Immunogen (Antigen) | synthetic peptide |
| Format | Liquid |
| Buffer Formulation | 50% glycerol, PBS with 0.05% proclin300, pH7.3 |
| Reactivity | Human, Mouse, Rat |
| Uniprot ID | 3976 |
| Gene ID | P15018 |
| Purification | Antigen-specific affinity chromatography followed by Protein A affinity chromatography |
| Usage | For Research Use Only. Not for diagnostics or human use. |
| Shelf Life | 12 months at time of shipping |
| Shipping | Shipped in Dry Ice at -20 Degree Celsius |
| Storage | Store at -20 Degree Celsius. It is recommended to aliquot and store to avoid repeated freeze-thaw as it affects the stability of the antibody. |
| Research Areas | Cancer; Cell Biology; Immunology; Neuroscience; Growth Factors; Inflammation |
| KD/KO Validated | KD Validated |
| Disclaimer | The data indicated herein are as indicated and validated in our laboratory. These reagents are for research use only and not for in-vitro diagnostics or human use. |

![SFRP2 Rabbit Polyclonal Antibody [KD Validated]](https://www.kinesisdx.com/wp-content/uploads/2025/05/A22017_N18465_KO-WB_01-370x444.jpg)
![DNMT1 Rabbit Polyclonal Antibody [KD Validated]](https://www.kinesisdx.com/wp-content/uploads/2025/05/A16729_aN2135-5_WB_04-370x444.jpg)

![CYB5R3 Rabbit Polyclonal Antibody [KD Validated]](https://www.kinesisdx.com/wp-content/uploads/2025/05/A24755_N30496-4_WB_01-370x444.jpg)
![CTCF Rabbit Polyclonal Antibody [KD Validated]](https://www.kinesisdx.com/wp-content/uploads/2025/05/A18627_N6060-4_KO-WB_01-370x444.jpg)
![CLIC1 Rabbit Polyclonal Antibody [KD Validated]](https://www.kinesisdx.com/wp-content/uploads/2025/05/A23677_N26852-4_IF_01-370x444.jpg)
Reviews
There are no reviews yet.